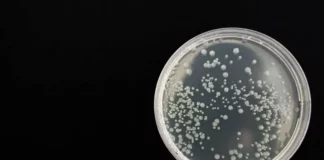
В Бургас спасиха жена от бактерия, която убива за часове

Етикети: бактерия
Последвайте ни
Водещи новини
Николай Нанков: Следващата ни цел е да изравним жизнения стандарт на българите със средните...
Ще водим позитивна кампания, ще сме градивни, ще обещаваме само това, което можем да изпълним - както винаги досега, пише депутатът от ГЕРБ "ГЕРБ-СДС влизаме...
Настъпи астрономическата пролет
С деня на пролетното равноденствие светлата част на деня започва да се увеличава Астрономическата пролет настъпи точно в 16:46 ч. българско време. С деня на...
Представиха първия нов влак „Шкода“ у нас, очакват се още до лятото
Договорът беше подписан от кабинета "Желязков" Първият нов електрически влак „Шкода“ у нас беше представен на Централна гара София от служебния министър на транспорта и...
Разкриха още един незаконен дом за възрастни хора край Варна
Работел под формата на стаи за гости Незаконен дом за възрастни хора, който работи под формата на стаи за гости, бе установен в местността "Ален...
Сарафов е в Хага на среща на главните прокурори от страните, членки на ЕС
Форумът се провежда в централата на Евроджъст
И.ф. главен прокурор на Република България Борислав Сарафов е на работно посещение в Хага, Кралство Нидерландия, за участие...
Най-четени
„Мяра“ дава на коалицията на Радев с 9,7% повече от „Маркет линкс“
6 партии влизат в парламента според проучването Социологическата агенция "Мяра" прогнозира 30,8% за коалицията „Прогресивна България" на бившия президент Румен Радев в проучването си, публикувано...
Трайчо Трайков: Печалбата от газопровода „Балкански поток“ само за 2025 г. е 560 млн....
Разходите по експлоатацията на инфраструктурата са в размер на 9,8 млн. лв. Печалбата от газопровода „Балкански поток“ за 2025 г. достига 560 млн. лв. (286...
Кой лъже – Кирил Петков или Лаура Кьовеши?
Съдът отхвърли искане на прокуратурата за експертиза на изявление на Кьовеши вчера в европарламента Софийският градски съд отхвърли искане на прокурор Ангел Кънев по делото...
Борисов: Влизането в Съвета за мир на Тръмп беше решение на ГЕРБ, Пеевски няма...
Гюров ще е премиер още месец, а тръгна да решава международни въпроси, вместо да види цените, спекулата и горивата, посочи лидерът на ГЕРБ Лидерът на...
Шест държави са готови да помогнат за сигурността в Ормузкия проток
Сред тях са Франция и Великобритания
Франция, Великобритания, Германия, Италия, Нидерландия и Япония осъдиха иранските атаки срещу гражданска енергийна инфраструктура в Персийския залив и заявиха,...